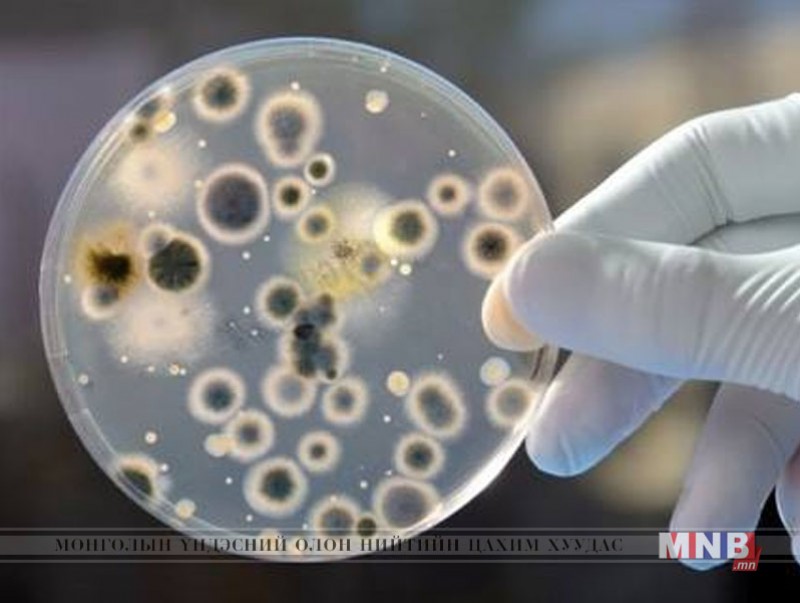

Хүнсний бүгээгдэхүүнийг эрүүл ахуйн шаардлага хангахгүй чийгтэй, халуун нөхцөлд худалдаалах, тээвэрлэх, хадгалах нь хүнсэнд хөгц мөөгөнцөр үүсэхэд хүргэдэг.
ИЙМД ИРГЭН ТА БҮҮ МАРТ!!!
Бүх төрлийн хүнсийг хөгц мөөгөнцөр болон микотоксиноор бохирдуулахгуйн тулд тухайн бутээгдэхууний шошгонд заагдсан тохирсон чийглэг болон температурт зөв хадгалах нъ чухал.
Хүнсний бутээгдэхүүнд нэгэнт үүссэн хөгц мөөгөнцрийн хор нь хунсний бутээгдэхүүнийг бэлтгэх, халуун боловсруулалт хийх явцад устдаггүй болно.
Хөгц нь хүнсний бүтээгдэхүүний зөвхөн нүдэнд харагдах гадаргуу хэсэгт бус, гүн рүү нь ургасан байдаг ба түүний гэмтээгүй хэсэгт нь ч (ялангуяа чийглэг өндөртэй бутээгдэхүүнд) хөгц мөөгөнцрийн хор ялгарсан байх аюултай тул тухайн бутээгдэхүүнийг шууд хаях хэрэгтэй.
| Хөгц мөөгөнцөр | ||
| Үзсэн: 5736 | Mongolian National Broadcaster |


 Үндэсний телевиз
Үндэсний телевиз





















































































































 Р.Слава
Р.Слава

 Б.Цоожчулуунцэцэг
Б.Цоожчулуунцэцэг

 М.Тодхүү
М.Тодхүү





Сэтгэгдэл бичих:
АНХААРУУЛГА: Уншигчдын бичсэн сэтгэгдэлд MNB.mn хариуцлага хүлээхгүй болно. ТА сэтгэгдэл бичихдээ хууль зүйн болон ёс суртахууны хэм хэмжээг хүндэтгэнэ үү. Хэм хэмжээг зөрчсөн сэтгэгдэлийг админ устгах эрхтэй. Сэтгэгдэлтэй холбоотой санал гомдолыг 70127055 утсаар хүлээн авна.